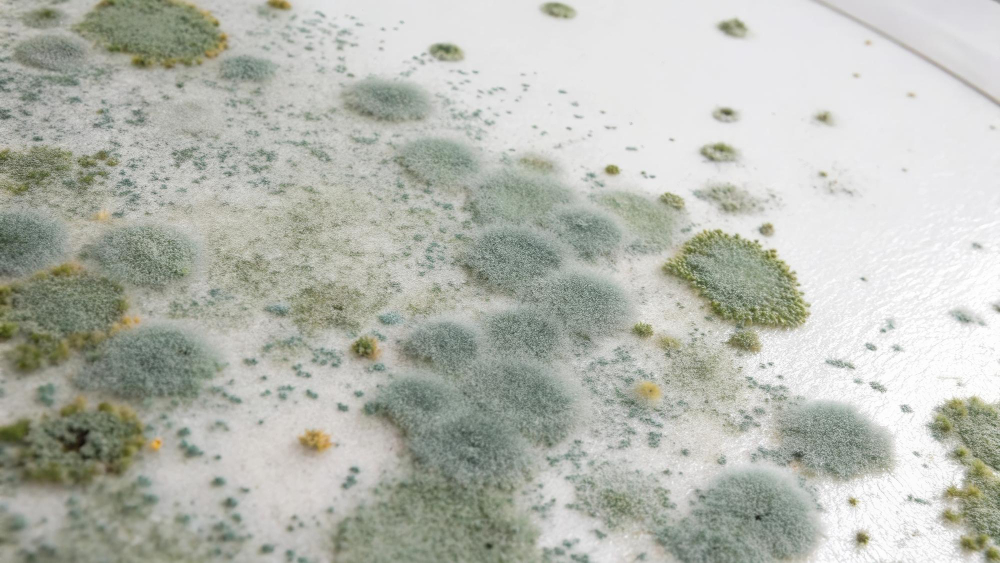
ריח של עובש מסוכן ריח של עובש מסוכן

כולנו מכירים את זה: ריח מוזר, מעט מעופש, שחודר לאף ומסרב לעזוב. אולי באמבטיה, אולי בארון הבגדים, או אולי, רחמנא לצלן, במרכז הסלון. רובנו נוטים לפטור אותו במשיכת כתף – "אה, קצת לחות," או "צריך לאוורר." אבל מה אם נגיד לכם שהריח הלא מזיק לכאורה הזה הוא בעצם קריאת אזהרה עוצמתית מהבית שלכם, אות שמצביעה על סכנה שקטה ועוצמתית שמתחבאת מעבר לפינה? כן, בדיוק כמו שאתם חושבים.
הריח הזה, שמגיע אלינו לרוב מאזורים רטובים או לחים, הוא לא רק מטרד אסתטי. הוא סמן לבעיה עמוקה יותר, שעלולה להשפיע לא רק על המבנה שלכם, אלא גם, וחשוב מכך, על הבריאות של כל מי שגר בו.
אז לפני שאתם ממהרים לדלג לפסקה הבאה, בואו נצלול לעומק העולם הנסתר של הריחות הלא נעימים, נבין למה הם כל כך משמעותיים, ואיך אתם יכולים לזהות את הסימנים המוקדמים שיצילו אתכם מצרות גדולות באמת. מוכנים לגלות את האמת המטרידה (והאפשרויות המרגיעות לפתרון)? יאללה, בואו נתחיל!

הניחוח המוזר באוויר: האם הוא רק מטרד או קריאת השכמה מסוכנת לבית שלכם?
בואו נודה באמת: החיים שלנו מלאים בריחות. יש את ריח הקפה בבוקר, ריח האוכל המבושל, ואפילו ריח הגשם הראשון על האדמה היבשה. אבל יש גם ריחות אחרים. כאלה שגורמים לנו להרים גבה, להתכווץ קצת באף, ולפעמים גם לחפש מהר את הדאודורנט הקרוב. הריח העבש. המנומנם. המטונף משהו. הוא שם. הוא מרחף. והוא, רבותיי, הגיבור (או הנבל, תלוי איך מסתכלים על זה) של המאמר הזה.
האם הוא רק סימן לזה שהגיע הזמן לנקות את המקרר? או אולי מדובר במשהו הרבה יותר משמעותי? ובכן, ברוב המקרים, כשמדובר בריח עובש, התשובה היא שהשעון המעורר כבר צלצל, והוא דורש מאיתנו להקשיב. לא רק להקשיב, אלא גם לפעול. כי הריח הזה הוא לא בדיחה, והוא בהחלט לא סתם "קצת לחות". הוא סיפור. סיפור על מים, על חושך, על הזנחה, ועל אורגניזם קטן ועיקש שמתפתח לו בשקט, ועלול להפוך לבעיה ענקית.
האם אי פעם עצרתם לחשוב ממה בעצם מורכב הריח המיוחד הזה? הוא לא סתם "ריח של רטיבות". הוא שילוב של מולקולות כימיות נדיפות (Volatile Organic Compounds – VOCs) שהעובש משחרר לסביבה. המולקולות האלה, שנקראות גם MVOCs (Microbial Volatile Organic Compounds), הן אלו שמספרות לנו שהעובש חי, בועט, ובעיקר – מתפשט.
הן תוצרי לוואי של תהליכים מטבוליים של העובש. כלומר, העובש נושם, אוכל, ומשחרר את הריח הזה כחלק טבעי מהקיום שלו. אז בפעם הבאה שאתם מריחים את הריח העבש הזה, דעו לכם שאתם מריחים למעשה את המסיבה שהעובש חוגג בבית שלכם. וזה, תאמינו לי, לא סוג המסיבה שאתם רוצים להצטרף אליה.
שאלות ותשובות מהירות: האם כל ריח 'עובשי' הוא בהכרח מסוכן?
- שאלה: אני מריח ריח עובש קל אחרי מקלחת חמה, האם זה מסוכן?
- תשובה: ריח עובש קל אחרי מקלחת עשוי להעיד על הצטברות לחות. אם הריח נעלם לאחר אוורור טוב והמקום מתייבש לחלוטין, ייתכן שזה לא מצביע על בעיה חמורה מיידית. עם זאת, אם הריח נשאר, מחמיר, או מופיעים כתמי עובש, זוהי קריאת אזהרה שדורשת התייחסות.
- שאלה: יש לי ריח עובש קבוע באזור מסוים בבית, אבל אני לא רואה כלום. מה זה אומר?
- תשובה: זהו אחד הסימנים המסוכנים ביותר. עובש יכול להתפתח מאחורי קירות גבס, מתחת לריצוף, בתוך תעלות מיזוג אוויר או בעליית הגג, כלומר במקומות שאינם נראים לעין. הריח הוא העדות היחידה לקיומו, וזה בהחלט דורש בדיקה מקצועית מיידית.
- שאלה: האם עובש "טרי" פחות מסוכן מעובש "ישן"?
- תשובה: לא בהכרח. סכנת העובש אינה תלויה ב"גיל" שלו, אלא בסוג העובש, בכמות הנבגים והרעלנים שהוא משחרר, וברגישות האנשים שנחשפים אליו. עובש "טרי" יכול להיות מסוכן לא פחות, ואף יותר, אם הוא מתפשט במהירות.
הקסם ה'מיוחד' של העובש: למה הוא בכלל נוצר?
אם נדמה לכם שהעובש מופיע משום מקום, אתם טועים. העובש הוא לא קסם שחור ולא קונספירציה. הוא אורגניזם חי, פטרייה ליתר דיוק, שפשוט מחפש את התנאים המושלמים להתפתח ולשגשג. ובדיוק כמו כל יצור חי, גם לעובש יש דרישות בסיסיות לחיים. והחדשות הרעות הן שבתים רבים, מבלי שנדע, מספקים לו את כל מה שהוא צריך. אז מה הם שלושת הגורמים הסודיים שהופכים את הבית שלנו לגן עדן לעובש?
1. מים, מים, מים: המרכיב החשוב ביותר (והכי הרסני)
זה לא סוד – עובש אוהב מים. הוא פשוט לא יכול בלעדיהם. אם יש מקום שבו הייתה הצפה, דליפה, רטיבות כלואה, עיבוי קבוע, או כל מקור לחות אחר שנמשך יותר מ-24-48 שעות – העובש כבר אורז מזוודות ועובר לגור שם. רטיבות היא הגורם מספר אחד להיווצרות עובש, וזו הסיבה שאחרי נזקי מים, בין אם מדובר בצנרת שהתפוצצה, גשם שחדר פנימה, או הצפה אמיתית, חובה לטפל בייבוש המוחלט של המבנה והתכולה. כי כל טיפה שנותרה מאחור היא הזמנה פתוחה למסיבת עובש.
2. מזון: הפינוק שהעובש פשוט לא יכול לסרב לו
אנחנו אולי חושבים על עובש שמתפתח על לחם או גבינה, אבל בבית, המזון של העובש הוא הרבה יותר מגוון. הוא ניזון מחומרים אורגניים שנמצאים כמעט בכל מקום: עץ, גבס, טקסטיל, אבק, לכלוך, נייר, ובקיצור – כל מה שבניתם איתו את הבית שלכם, או הכנסתם לתוכו. הוא פשוט מפרק את החומרים האלה ומשתמש בהם כמקור אנרגיה. אז ככל שהבית "מלוכלך" יותר או מלא יותר בחומרים אורגניים, כך תפריט המסעדה של העובש עשיר ומגוון יותר. אגב, גם צבעי קיר מסוימים, ובמיוחד כאלה המבוססים על לטקס, יכולים לשמש לו כמזון משובח.
3. טמפרטורה וחשיכה: הסביבה המושלמת למסיבה
עובש מעדיף טמפרטורות חמימות יחסית (אך מסוגל לשרוד גם בקור). בנוסף, הוא מעדיף סביבה חשוכה או עם תאורה מועטה, מכיוון שאור UV טבעי (שמש) פוגע בנבגיו. לכן, מקומות כמו מאחורי ארונות, בתוך קירות, מתחת לכיורים, בעליות גג לא מאווררות או במרתפים לחים וחשוכים, הם בתי הגידול האידיאליים עבורו. חוסר אוורור גם תורם באופן משמעותי, שכן הוא מאפשר ללחות להצטבר ולנבגים "להתיישב" ללא הפרעה.
אז אם נסכם, עובש לא מופיע סתם. הוא תוצאה של שילוב קטלני של רטיבות, חומרים אורגניים וסביבה נוחה ונסתרת. זיהוי אחד מהגורמים הללו בזמן, ובמיוחד רטיבות, הוא הצעד הראשון והחשוב ביותר במניעת התפתחותו.
זה לא רק ריח רע: המולקולות שמספרות סיפור (מפחיד לעיתים)
כשאנחנו מריחים ריח עובש, אנחנו לא מריחים רק "לחות" או "בֵּאוּשׁ". אנחנו מריחים עדות חיה ונושמת לכך שאורגניזם זעיר וחמקמק עובד במרץ, משחרר לאוויר חומרים שאנחנו לא רוצים לנשום. ובואו נהיה ברורים: החומרים האלה הם לא בושם. הם מולקולות שעלולות להיות בעייתיות למדי, ושתי הקטגוריות העיקריות שלהן הן ה-MVOCs שדיברנו עליהם, וקטגוריה הרבה יותר מפחידה: ה-מיקוטוקסינים.
MVOCs: ה"בושם" של העובש שמבשר רעות
ה-MVOCs הם, כאמור, תרכובות אורגניות נדיפות שנוצרות על ידי העובש. הן אלו שמעניקות לעובש את הריח האופייני שלו – אותו ריח "אדמתי", "מעופש" או "מתוק-דחוי" שרבים מאיתנו מכירים.
מחקרים מראים שחשיפה ממושכת ל-MVOCs, גם אם בריכוזים נמוכים, עלולה לגרום לגירויים בדרכי הנשימה, כאבי ראש, בחילות, עייפות, ובמקרים מסוימים אפילו לפגיעה קוגניטיבית. זה קצת כמו להיות ליד מפעל כימי קטן, סמוי מהעין, שפועל 24/7 בתוך הבית שלכם.
מיקוטוקסינים: הרעלנים האמיתיים שאי אפשר להריח
אבל הסיפור האמיתי, והמפחיד הרבה יותר, הוא המיקוטוקסינים. אלו הם חומרים רעילים שחלק מסוגי העובש (כמו ה"עובש השחור" הידוע לשמצה, Stachybotrys chartarum, או סוגים מסוימים של Aspergillus ו-Penicillium) מייצרים. בניגוד ל-MVOCs, למיקוטוקסינים אין ריח. כלומר, אתם יכולים להיות בסביבה רוויה במיקוטוקסינים מסוכנים, ופשוט לא להריח כלום. אבל הם שם, מרחפים באוויר, נצמדים לחלקיקי אבק, ונכנסים לגוף שלכם דרך מערכת הנשימה, העור או אפילו מערכת העיכול.
חשיפה למיקוטוקסינים עלולה להיות מסכנת חיים במקרים חמורים, ולגרום למגוון רחב של תסמינים, מבעיות נשימה קשות, דרך פגיעה במערכת העצבים, ועד לדיכוי מערכת החיסון ואף סרטן במקרים קיצוניים של חשיפה ממושכת ורבה. זו הסיבה שריח העובש, גם אם הוא רק מבשר על MVOCs, הוא דגל אדום ענק. הוא אומר לנו: "היי, יש פה עובש! ואם יש עובש, מי יודע אם הוא גם מייצר מיקוטוקסינים?"
לכן, אל תזלזלו בריח העבש. הוא השגריר של בעיה פוטנציאלית חמורה. הוא המודיע שבא להזהיר. והקשבה לו היא הצעד הראשון להגנה על הבריאות שלכם ושל משפחתכם.
מתי הגוף צועק: 7 סימני אזהרה שאסור לכם להתעלם מהם!
הריח הוא, כאמור, סימן אזהרה חשוב. אבל מה קורה כשהעובש מתחיל לדבר גם דרך הגוף שלנו? חשיפה לעובש, ל-MVOCs ולמיקוטוקסינים, עלולה לגרום למגוון רחב של תסמינים. אלו לא סתם "צירופי מקרים" או "סתם עייפות". אלו קריאות השכמה מהגוף, שמנסה להתמודד עם פולש לא רצוי. בואו נראה אילו סימנים הגוף שלכם עלול לשלוח לכם, ומדוע חשוב להקשיב להם:
1. התקפות אלרגיה בלתי מוסברות: סיפור יומיומי של סבל
אם אתם או בני משפחתכם סובלים מאלרגיות, חשיפה לעובש יכולה להפוך את החיים לסיוט. נזלת כרונית, התעטשויות בלתי פוסקות, עיניים דומעות ומגרדות, גירויים בעור, פריחות ואפילו החמרה של אקזמה – כל אלו יכולים להיות תוצאה ישירה של נבגי עובש המרחפים באוויר. הבית, שאמור להיות המבצר הבטוח שלכם, הופך למעשה למקור סבל בלתי פוסק.
2. קשיי נשימה, שיעול וצפצופים: ההתקפה על הריאות
לאנשים הסובלים מאסטמה או מבעיות נשימה אחרות, עובש הוא גורם סיכון ממשי. הוא עלול לגרום להתקפי אסטמה תכופים וחמורים יותר, קוצר נשימה, שיעול כרוני (יבש או עם ליחה), צפצופים בנשימה, ותחושה של לחץ בחזה. גם אנשים בריאים ללא היסטוריה של בעיות נשימה עלולים לפתח שיעול וקשיי נשימה עקב חשיפה ממושכת לעובש.
3. עייפות כרונית, כאבי ראש ו"ערפול מוחי": המאבק הנסתר
אחד הסימנים הפחות מוכרים, אך הנפוצים ביותר, לחשיפה לעובש הוא עייפות בלתי מוסברת, כאבי ראש חוזרים ונשנים, ומה שמכונה "ערפול מוחי" (Brain Fog) – קשיי ריכוז, בעיות זיכרון, וקושי בחשיבה צלולה. הגוף נמצא במצב של מלחמה מתמדת נגד הרעלנים, מה שגוזל ממנו אנרגיה רבה ומשפיע על התפקוד הקוגניטיבי.
4. בעיות עור וגירויים: כשהעור מגיב
מעבר לפריחות אלרגיות, חשיפה לעובש עלולה לגרום לגירויים כלליים בעור, אדמומיות, יובש, ואפילו התפתחות של פצעים קטנים. העור, שהוא המחסום הגדול ביותר בגוף, מגיב למגע עם נבגים או חומרים מגרים אחרים שמקורם בעובש.
5. כאבי פרקים ושרירים: תגובה דלקתית בגוף
ישנם דיווחים רבים על קשר בין חשיפה לעובש לבין כאבי פרקים ושרירים בלתי מוסברים, ולעיתים אף פיברומיאלגיה. חשיפה לרעלני עובש עלולה לעורר תגובה דלקתית סיסטמית בגוף, שמתבטאת בכאבים אלה.
6. בעיות עיכול: כשהבטן מתהפכת
בחילות, הקאות, שלשולים, וכאבי בטן יכולים גם הם להיות קשורים לחשיפה לעובש, במיוחד אם המיקוטוקסינים נבלעים בדרך כלשהי (למשל, על ידי אכילת מזון שזוהם בעובש או במגע ידיים מזוהמות עם הפה). מערכת העיכול מגיבה לרעלנים הללו ומנסה להיפטר מהם.
7. מצב רוח ירוד ודיכאון: ההשפעה על הנפש
הקשר בין חשיפה לעובש למצב נפשי הוא נושא שמתחיל לקבל יותר ויותר תשומת לב. עייפות כרונית, תסמינים פיזיים מתמשכים, ודאגה מתמדת לבריאות, עלולים להוביל למצב רוח ירוד, חרדה, ואף דיכאון. המלחמה הבלתי נראית הזו גובה מחיר לא רק מהגוף, אלא גם מהנפש.
אם אתם מזהים אחד או יותר מהסימנים הללו, במיוחד אם הם מופיעים או מחמירים כשאתם נמצאים בבית, ונרגעים כשאתם מחוצה לו, זהו דגל אדום בוהק. אל תתעלמו מהם. גשו לבדיקה רפואית, ובמקביל, התחילו בחיפוש יסודי למקור העובש בביתכם. הבריאות שלכם תלויה בזה.
שאלות ותשובות מהירות: האם אפשר שיהיה עובש בלי שיהיה ריח?
- שאלה: אני לא מריח כלום, אבל יש לי כתמי עובש קטנים באמבטיה. האם זה עדיין מסוכן?
- תשובה: כן, בהחלט. העובדה שאתה רואה כתמי עובש פירושה שהם כבר נוכחים ומתפתחים, גם אם הריכוז שלהם עדיין לא מספיק גבוה כדי ליצור ריח מורגש או שהם לא מייצרים הרבה MVOCs. כל עובש הוא פוטנציאל לסכנה בריאותית ויש לטפל בו.
- שאלה: האם עובש יכול להיות קיים בלי שאראה אותו או אריח אותו?
- תשובה: בהחלט. זהו אחד התרחישים המסוכנים ביותר. עובש יכול להתפתח עמוק בתוך קירות, מאחורי ארונות, בתעלות מיזוג אוויר סגורות, או מתחת לריצוף. במקרים אלו, הוא עלול לשחרר מיקוטוקסינים רעילים לסביבה שאינם בעלי ריח, ובכך לסכן את דיירי הבית בלי כל סימן חיצוני. רק בדיקה מקצועית תוכל לזהות אותו.
- שאלה: אם אין ריח, האם אני יכול פשוט לנקות את העובש עם אקונומיקה?
- תשובה: ניקוי עם אקונומיקה הוא פתרון נקודתי בלבד לכתמים קטנים ושטחיים, וגם אז הוא לא תמיד יעיל ואף עלול להזיק (לגרום לחומרים רעילים להתפשט). כאשר מדובר בעובש שנראה או שאינו נראה אבל משפיע בריאותית, ובמיוחד אם הוא נובע מבעיית רטיבות מתמשכת, יש צורך בטיפול שורש מקצועי הכולל ייבוש יסודי, סילוק העובש ומניעת חזרתו. אקונומיקה לא תטפל במקור הבעיה.
מעבר לריח ולראייה: היכן העובש מתחבא בבית ואיך מוצאים אותו?
העובש הוא אומן הסוואה אמיתי. הוא לא תמיד יופיע מול העיניים שלנו בצורת כתם ירוק-שחור בולט. לעיתים קרובות, הוא מעדיף את החושך והלחות של המקומות הנסתרים ביותר בבית. ולכן, מעבר לריח המטריד, חשוב לדעת איפה לחפש את הפולש השקט הזה. כי אם לא תמצאו אותו, הוא ימצא אתכם.
1. מאחורי הקלעים: קירות גבס, מתחת לריצוף ובתוך ארונות
נזילות צנרת קטנות ולא מטופלות, רטיבות כלואה מתחת לריצוף (אחרי הצפה שלא יובשה היטב) או סדק קטן בקיר חיצוני שמאפשר חדירת מים – כל אלה יכולים ליצור סביבה מושלמת לעובש להתפתח בתוך הקירות, מתחת לריצוף או מאחורי ארונות מטבח וחדרי אמבטיה. הריח הוא לעיתים הסימן היחיד, יחד עם שינויים קלים בצבע הקיר או בטקסטורה שלו (למשל, התנפחות קלה של צבע או גבס). זו הסיבה שהעובש מכונה לעיתים "המחלה השקטה של הבית".
2. ברום השמיים: עליות גג ותקרות נמוכות (מבט למעלה)
בעיות איטום בגג, עיבוי לחות עקב בידוד לקוי או אוורור לא מספק, יכולים להוביל להתפתחות עובש בעליית הגג או בתקרות. לעיתים קרובות, הכתמים יופיעו בתחילה בצורת עיגולים צהבהבים או חומים, ורק בהמשך יקבלו את הגוון השחור או הירוק האופייני לעובש. הריח עשוי להיות מורגש רק בחדרים הסמוכים או בזמן עליה לעליית הגג.
3. במעבה האדמה: מרתפים וחללי זחילה (מישהו אמר "לחות"?)
מרתפים וחללי זחילה הם גן עדן לעובש. הם לרוב חשוכים, לחים, סגורים ולא מאווררים. חדירת מים מהיסודות, צינורות דולפים או פשוט לחות גבוהה באוויר, הופכים אותם למצע גידול אידיאלי. הריח העבש שעולה מהמרתף הוא אינדיקציה כמעט ודאית לבעיה. שימו לב גם לכתמי רטיבות על הקירות והרצפה, ולסימני קורוזיה על צינורות מתכת.
4. בתוך מערכת הנשימה של הבית: תעלות מיזוג אוויר
תעלות מיזוג אוויר הן מקום נפלא לעובש להתחבא. הן חשוכות, לחות (בגלל עיבוי מים), ומלאות באבק ולכלוך שיכולים לשמש כמזון. כשהמזגן פועל, הוא מפיץ את נבגי העובש והריח בכל הבית. אם אתם מריחים ריח עבש כשאתם מפעילים את המיזוג, זוהי קריאת אזהרה ברורה שדורשת בדיקה וניקוי מקצועי של התעלות.
5. היכן שפחות מצפים: ספרים, רהיטים, שטיחים ובגדים
כל חומר אורגני סופג לחות יכול לשמש כמצע לעובש. ספרים ישנים במדפים סגורים, ריפודים של ספות, שטיחים ואפילו בגדים בארונות סגורים – כולם יכולים לפתח עובש אם רמת הלחות גבוהה. חפשו כתמים קטנים, שינויי צבע, או פשוט העבירו את היד ותראו אם יש תחושה של "קטיפתיות" או עובש קל. הריח יהיה לרוב מורגש רק מקרוב.
איתור עובש דורש עין חדה, אף רגיש, ולעיתים קרובות – גם ציוד מקצועי. אם אתם חושדים שיש לכם עובש נסתר, אל תנסו להיות בלשים לבדכם. זה הזמן לקרוא למומחים שיש להם את הכלים והידע למצוא את הבעיה ולטפל בה מהשורש.
האומנות של ה'לא לעשות כלום': למה טיפול עצמי בעובש הוא מתכון לאסון?
בואו נהיה כנים. אנחנו אוהבים אתגרים. אנחנו אוהבים "לתקן דברים לבד". "אני אקונומיקה ואני אפתור הכל!", אנחנו אומרים לעצמנו, עם חיוך קטן של ביטחון עצמי. אבל כשזה מגיע לעובש, העיקרון של "DIY" (עשה זאת בעצמך) הוא לא רק לא יעיל – הוא עלול להיות מסוכן ממש. לא רק לכם, אלא לכל הבית שלכם. אז למה כדאי לשכוח מפתרונות "סבתא" ו"אני קראתי באינטרנט"?
1. למה פתרונות 'סבתא' לא עובדים (ולא, אקונומיקה היא לא קסם)
אקונומיקה, חומץ, אבקת סודה לשתייה – כל אלו עשויים לעזור להלבין כתמי עובש על משטחים קשים ולא נקבוביים כמו אריחי קרמיקה. אבל זוהי אשליה אופטית. הם הורגים את העובש שעל פני השטח, אך הם אינם חודרים לעומק החומר. נבגי העובש והשורשים (הידועים כהיפות) נשארים בפנים, וברגע שתחזור הלחות, העובש יצוץ שוב, חזק ובועט יותר מבעבר. אקונומיקה, למשל, מורכבת בעיקר ממים. המים האלה נספגים בחומרים נקבוביים כמו עץ או גבס, ומשמשים למעשה כמזון נוסף לעובש שנותר בפנים. בנוסף, חומרים אלה עלולים לפלוט אדים רעילים כשהם מתערבבים עם חומרים אחרים (כמו אמוניה), וגם לגרום לגירויים בעור ובדרכי הנשימה.
2. הסכנות שבפיזור נבגים: 'להזיז את העובש' למקום אחר
כשאנחנו מנסים לנקות עובש באופן עצמאי, במיוחד על משטחים יבשים או על ידי שפשוף אגרסיבי, אנחנו גורמים למעשה לנבגי העובש להתפזר באוויר. נבגים אלה הם זעירים, בלתי נראים לעין, ועלולים להתיישב באזורים אחרים בבית, וכך לגרום להתפשטות הבעיה במקום לפתור אותה. זה כמו לנסות לכבות שריפה על ידי פיזור גיצים בכל הבית. בנוסף, פיזור הנבגים מגביר את הסיכון לחשיפה בריאותית לכל מי שנמצא בבית.
3. אי זיהוי מקור הבעיה: הטיפול הוא רק פלסטר זמני
הדבר החשוב ביותר בעת טיפול בעובש הוא לזהות את מקור הרטיבות שהוביל להתפתחותו. האם זו נזילה? הצפה? עיבוי? איטום לקוי? בלי לטפל במקור הבעיה, כל ניקיון שתבצעו יהיה חסר טעם. העובש פשוט יחזור שוב ושוב. איתור מקור הרטיבות דורש לעיתים קרובות ציוד ייבוש מקצועי, מצלמות טרמיות, מדדי לחות ומומחיות שאנחנו, כבעלי בתים, פשוט לא מחזיקים בהם. אז במקום להתמודד עם "למה זה חזר שוב?!", כדאי להתמודד עם "למה זה קרה מלכתחילה?".
4. חשיפה בריאותית מיותרת: אל תהפכו לקורבנות
כפי שציינו, עובש עלול להיות מסוכן לבריאות. ניסיון לטפל בו ללא ציוד מיגון מתאים (מסכות מיוחדות, כפפות, חליפות הגנה) ובלי ידע מתאים, חושף אתכם ואת בני משפחתכם לנבגים, ל-MVOCs ולמיקוטוקסינים. הסיכון לפתח תסמינים בריאותיים מחשיפה זו עולה משמעותית. למה לקחת סיכון מיותר כשקיימים אנשי מקצוע שיכולים לעשות זאת בבטחה?
לסיכום, טיפול בעובש הוא לא עניין של "עשה זאת בעצמך". זוהי משימה שמחייבת ידע, ניסיון, וציוד מתאים. הניסיונות לחסוך כמה שקלים עלולים לעלות לכם הרבה יותר בטווח הארוך, הן בבריאות והן בנזק למבנה. תנו למומחים לעשות את מה שהם יודעים לעשות הכי טוב.
המדריך המלא לשיקום מקצועי: 5 צעדים להחזיר את הבית שלכם לחיים בביטחון
אחרי שהבנו כמה מסוכן הריח העבש, ועד כמה חשוב לא לנסות להיות גיבורים בטיפול בו, הגיע הזמן לדבר על הפתרון האמיתי. שיקום עובש מקצועי הוא תהליך מורכב, מדויק ויסודי, שמטרתו לא רק להעלים את הכתמים, אלא גם לחסל את מקור הבעיה, לייבש את הסביבה, ולמנוע חזרת עובש בעתיד. בואו נפרק את התהליך לצעדיו המרכזיים, כדי שתבינו בדיוק מה אתם מקבלים כשאתם מזמינים מומחים.
1. השלב הראשון: מיפוי הנזק והבנת האויב (היכן הוא מסתתר?)
לפני שמתחילים בכל עבודה, צוות השיקום יגיע למקום כדי לבצע הערכה מקיפה. זה לא סתם "מבט מהיר". זהו שלב קריטי שכולל:
- זיהוי מקור הרטיבות: באמצעות ציוד מתקדם כמו מצלמות תרמיות, מדדי לחות וחיישני מים, מאתרים את נקודת המקור של הרטיבות, גם אם היא חבויה בתוך קירות או מתחת לריצוף. בלי זה, אין טעם להמשיך.
- הערכת היקף הנזק: כמה גדול אזור העובש? האם הוא התפשט לחללים סמוכים? מהם החומרים שנפגעו (עץ, גבס, בטון, טקסטיל)?
- בדיקת סוג העובש: לעיתים, לקיחת דגימות לבדיקת מעבדה תעזור לזהות את סוג העובש, מה שמשפיע על פרוטוקול הטיפול ועל הערכת הסיכון הבריאותי.
- תכנון פעולה: על בסיס כל הנתונים, בונים תוכנית שיקום מפורטת הכוללת את השיטות, הציוד והזמנים המשוערים.
2. השלב השני: בידוד וביטחון – למנוע התפשטות (כמו מבצע צבאי)
כדי למנוע מנבגי העובש להתפשט לאזורים אחרים בבית במהלך הטיפול, יוצרים אזור בידוד. זהו שלב קריטי שיכול לכלול:
- איטום האזור הפגוע: באמצעות יריעות פלסטיק מיוחדות ואטומות.
- יצירת לחץ אוויר שלילי: משתמשים במפוחי אוויר ייעודיים עם פילטרים מתקדמים (HEPA) ששואבים את האוויר מהאזור המזוהם החוצה (או דרך הפילטרים), ובכך מונעים מנבגי עובש לברוח לחללים אחרים בבית.
- ציוד מיגון: צוות השיקום עובד עם ציוד מיגון אישי מלא (חליפות, מסכות, כפפות) כדי להגן על עצמו ועל הבית מפני זיהום.
3. השלב השלישי: סילוק העובש – לא להשאיר זכר (הקרב האמיתי)
זהו הלב של תהליך השיקום. בשלב זה, מסירים פיזית את העובש ואת כל החומרים שזוהמו בלתי הפיך:
- הסרת חומרים נגועים: כל חומר נקבובי שזוהם בעובש (גבס, עץ, בידוד, שטיחים, ריפודים) ואינו ניתן לניקוי וחיטוי יעיל, יוסר ויושלך באופן בטוח ומבוקר. זוהי נקודה חשובה: אי אפשר "להציל" כל חומר. לפעמים, ניתוח כואב הוא הפתרון היחיד.
- ניקוי משטחים קשים: משטחים שאינם נקבוביים (כמו בטון, מתכת, פלסטיק) ינוקו ביסודיות באמצעות חומרים ייעודיים וטכניקות ניקוי מקצועיות.
- שאיבת נבגים: שואבי אבק בעלי מסנני HEPA מיוחדים משמשים לשאיבת נבגי עובש וחלקיקים מזהמים מהאוויר ומהמשטחים.
4. השלב הרביעי: ייבוש, ניקוי וחיטוי – לנשום לרווחה (סוף סוף!)
אחרי שהעובש סולק, השלב הבא הוא לייבש את המקום ולטהר אותו:
- ייבוש יסודי: באמצעות מייבשים תעשייתיים, מפוחים וסופחי לחות חזקים, מייבשים את האזור לחלוטין. זה קריטי למנוע חזרת עובש. תהליך הייבוש נמשך לעיתים מספר ימים, ומנטרים אותו באמצעות מדדי לחות.
- חיטוי ונטרול ריחות: לאחר הייבוש, מבצעים חיטוי יסודי של כל המשטחים ונטרול ריחות באמצעות מכשור מיוחד (כמו מחוללי אוזון או מכונות טרמליות), שמסייעים להעלים את הריח העבש הנותר ולהשמיד בקטריות וחיידקים.
- ניקוי סופי: ניקוי יסודי של כל האזור מכל שאריות לכלוך או אבק.
5. השלב החמישי: מניעה – שלא נתראה שוב (אלא אם כן בא לכם קפה)
השלב האחרון הוא לדאוג שהבעיה לא תחזור. זה לא תמיד חלק ישיר מהטיפול הפיזי, אבל הוא חלק בלתי נפרד מגישה מקצועית:
- תיקון מקור הרטיבות: לוודא שמקור הנזילה/רטיבות תוקן באופן מוחלט.
- שיקום מבני: אם הוסרו קירות או ריצוף, מבצעים תיקונים מבניים והחזרת המצב לקדמותו.
- ייעוץ למניעה: מתן המלצות לבעלי הבית בנוגע לאוורור נכון, בקרת לחות, ותחזוקה שוטפת כדי למנוע הישנות הבעיה.
תהליך שיקום מקצועי הוא השקעה בבריאותכם ובערך הנכס שלכם. הוא מבטיח שהעובש לא רק ייעלם, אלא גם לא יחזור, ומאפשר לכם לנשום לרווחה בסביבה נקייה ובטוחה.
שאלות ותשובות מהירות: כמה זמן לוקח תהליך שיקום עובש?
- שאלה: יש לי כתם עובש קטן על הקיר, כמה זמן ייקח לכם לטפל בזה?
- תשובה: עבור כתם קטן ושטחי, הטיפול עצמו יכול לקחת מספר שעות. עם זאת, אם הכתם נובע מבעיית רטיבות עמוקה בתוך הקיר, תהליך הייבוש והשיקום המלא יכול להימשך מספר ימים עד שבוע, תלוי ברמת הרטיבות ובחומרים שנפגעו.
- שאלה: אחרי הצפה גדולה, כמה זמן אני צריך לצפות לתהליך שיקום מלא?
- תשובה: לאחר הצפה גדולה, תהליך השיקום מורכב יותר. שלב הייבוש בלבד יכול להימשך בין 3 ל-7 ימים, ובמקרים חמורים אף יותר. לאחר מכן, יש את שלב סילוק העובש (אם נוצר), חיטוי, ושיקום מבני, שיכולים להוסיף עוד שבוע עד שבועיים. סך הכל, צפו לכמה שבועות, אבל זה משתנה מאוד בהתאם להיקף הנזק.
- שאלה: האם אני יכול לחזור לבית בזמן תהליך השיקום?
- תשובה: תלוי בהיקף הבעיה. במקרים של עובש קל, ייתכן שתוכלו להישאר. אך כאשר מדובר בזיהום עובש משמעותי, ובמיוחד כאשר נוצרים אזורי בידוד ומערכות ייבוש, לרוב מומלץ מאוד לפנות את הבית למשך זמן הטיפול. זה מבטיח את ביטחונכם מפני חשיפה מיותרת לנבגים ורעלנים, ומאפשר לצוות לעבוד ביעילות מירבית.
ביטוחים ושמאים: איך העולם הבירוקרטי פוגש את העובש (והצפות)
התמודדות עם נזקי עובש, במיוחד אם הם נובעים מנזקי מים כמו הצפה או פיצוץ צנרת, עלולה להיות כאב ראש לא קטן, ולא רק בגלל הריח. לעיתים קרובות, מדובר בנזקים משמעותיים שעלולים להגיע לעשרות אלפי שקלים.
כאן נכנסות לתמונה חברות הביטוח והשמאים, והבנת התהליך איתם יכולה לחסוך לכם המון עוגמת נפש וכסף. החדשות הטובות הן שאם אתם עובדים עם חברת שיקום מקצועית, היא לרוב תדע בדיוק איך לנווט אתכם בעולם הבירוקרטי הזה.
1. מתי הביטוח נכנס לתמונה?
פוליסות ביטוח דירה (במיוחד כיסוי למבנה ולתכולה) כוללות לרוב סעיף של נזקי מים וצנרת. אם נזקי העובש נובעים מאירוע פתאומי ובלתי צפוי כמו פיצוץ צינור, דליפת מים מאיטום לקוי (במקרה שזה כלול בפוליסה) או הצפה – סביר להניח שהביטוח יכסה את עלויות השיקום. עם זאת, חשוב לדעת שביטוח לרוב לא יכסה נזקי עובש שהתפתחו עקב הזנחה מתמשכת, או אם לא טופלה בעיית רטיבות ידועה במשך זמן רב. לכן, כלל האצבע הוא: ככל שתפעלו מהר יותר לטפל בנזק, כך גדלים הסיכויים שהביטוח יכסה את עלויות השיקום.
2. תפקיד השמאי: עין מקצועית מול הביטוח
כאשר אתם מגישים תביעה לחברת הביטוח, היא תשלח שמאי מטעמה. תפקיד השמאי הוא להעריך את היקף הנזק, את הסיבה לו, ואת עלות התיקון. חשוב לדעת שהשמאי של חברת הביטוח מייצג את האינטרסים של חברת הביטוח. לכן, עבודה עם חברת שיקום מנוסה שיודעת לתעד את הנזק בצורה מקצועית, להציג דוחות ברורים, ולעמוד מול שמאי הביטוח, היא יתרון עצום. היא מבטיחה שהנזק לא יוערך בחסר ושאתם תקבלו את הכיסוי המגיע לכם.
3. תיעוד הוא המפתח: צלמו הכל!
מהרגע שאתם מזהים ריח עובש או נזילת מים, התחילו לתעד. צלמו תמונות וסרטונים של האזור הפגוע, של מקור הרטיבות (אם ידוע), ושל כל התכולה שנפגעה. שמרו קבלות על כל הוצאה שקשאת לתהליך (בדיקות, פינוי, ניקיון). ככל שיהיה לכם יותר תיעוד, כך יהיה קל יותר להוכיח את היקף הנזק מול חברת הביטוח.
4. חברת שיקום כשותפה: הניווט הנכון
חברות שיקום רבות, ובמיוחד כאלה עם ניסיון רב שנים, עובדות באופן שוטף מול חברות ביטוח ושמאים. הן יודעות מה חברות הביטוח דורשות, איך להגיש את המסמכים הנכונים, ואיך לתעד את התהליך באופן שמקובל על השמאים. היכולת הזו לחסוך לכם אינספור שיחות טלפון, בירוקרטיה ועוגמת נפש. הן יהיו ה"קול" המקצועי שלכם מול הביטוח ויבטיחו שתקבלו את הטיפול המלא וההולם.
אז אם נזק העובש שלכם נובע מנזק מים, אל תשכחו לערב את חברת הביטוח, ואל תהססו להיעזר במומחיות של חברת השיקום גם בהיבט הזה. זה יכול להציל לכם לא רק את הבית, אלא גם את הכיס.
החיים אחרי העובש: טיפים לבית נקי, בריא ונטול ריחות (מעובש, לפחות)
אחרי שסיימתם את תהליך השיקום המקצועי, הבית שלכם שוב נקי, בריא ונטול עובש. אבל זה לא אומר שאתם יכולים לשבת בחיבוק ידיים. מניעה היא המפתח כדי שהריח העבש והאורחים הלא רצויים לא יחזרו. הנה כמה טיפים פרקטיים שיעזרו לכם לשמור על הבית שלכם כמו שצריך:
1. אוורור, אוורור ועוד פעם אוורור: נשמו עמוק!
אחד האויבים הגדולים של העובש הוא אוויר טרי וזרימת אוויר טובה. הקפידו לאוורר את הבית באופן קבוע, במיוחד אחרי מקלחות, בישול או כביסה. פתחו חלונות, השתמשו בוונטות במטבח ובחדרי הרחצה, ואל תחסמו פתחי אוורור. אוויר עומד ולח הוא הזמנה פתוחה לעובש.
2. בקרת לחות: הכלים למלחמה בלחות יתרה
רמת לחות אידיאלית בבית צריכה להיות בין 30% ל-50%. קנו מד לחות (היגרומטר) והשתמשו בו. אם הלחות גבוהה מדי, שקלו להשתמש במסירי לחות (קונדנסורים) באזורים בעייתיים כמו מרתפים, חדרי אמבטיה או חדרי כביסה. וודאו גם שייבוש כביסה מתבצע באזור מאוורר היטב, עדיף מחוץ לבית.
3. טיפול מהיר ברטיבות: לא להמתין לדקה ה-90
ראיתם נזילה? צינור דולף? הצפה קטנה? טפלו בזה מיד! אל תחכו. כל עיכוב בטיפול ברטיבות נותן לעובש את הזמן היקר שהוא צריך כדי להתפתח. יבשו כל משטח רטוב בתוך 24-48 שעות. זהו הכלל החשוב ביותר במניעת עובש.
4. ניקיון שוטף ותחזוקה: קצת מאמץ שווה המון
נקו באופן קבוע אזורים מועדים ללחות כמו חדרי אמבטיה ומטבחים. שימו לב במיוחד לאזורים סביב ברזים, כיורים ומקלחות. בדקו באופן שוטף את אטמי הסיליקון סביב אמבטיות וכיורים והחליפו אותם אם הם מתבלים או מתחילים להעלות עובש. אל תשכחו לנקות את פתחי הניקוז ולהיפטר מלכלוך ואבק שצוברים לחות.
5. בדיקת מערכות: ממיזוג אוויר ועד גגות
בצעו בדיקות תקופתיות למערכות מיזוג האוויר (ניקוי פילטרים, בדיקת תעלות), לגג (חיפוש סדקים או בעיות איטום), ולמרזבים (וודאו שהם אינם סתומים ומנקזים את המים היטב הרחק מהיסודות של הבית). תחזוקה מונעת היא ההגנה הטובה ביותר.
זכרו, בית נקי מעובש הוא בית בריא יותר. עם קצת תשומת לב ותחזוקה שוטפת, תוכלו להבטיח שהריח העבש יישאר רק זיכרון רחוק, ושתמשיכו ליהנות מהבית שלכם בראש שקט, ונשימה עמוקה, ובלי אף קריאת אזהרה מטרידה מהקירות. בסופו של יום, הבית שלכם הוא המקום הבטוח שלכם, ועם הכלים הנכונים, הוא יישאר כזה.
לכן, בפעם הבאה שאתם מריחים את הריח המעופש הזה, או רואים אפילו שמץ של כתם חשוד, אל תהססו. זה לא הזמן להתלבט, אלא הזמן לפעול בחוכמה ובמהירות. הבריאות שלכם ושל יקיריכם, יחד עם שלמות ביתכם, שוות כל מאמץ והשקעה. וכן, אנחנו כאן כדי לוודא שתוכלו לחזור לנשום אוויר צח, נקי ובריא.
